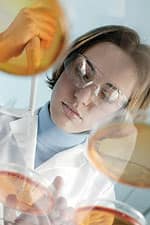
Anti-Cancer Effects

Life Extension Magazine®
In 1997, the Life Extension Foundation® warned that taking only the alpha tocopherol form of vitamin E could displace critically important gamma tocopherol in the body. While alpha tocopherol inhibits the production of new free radicals, gamma tocopherol is required to trap and neutralize existing free radicals. Three years after Life Extension’s announcement, the Johns Hopkins School of Public Health released the results of a huge study (10,456 men). The startling findings showed that men with the highest gamma tocopherol blood levels had a five-fold reduction in prostate cancer risk. This same study showed that selenium and alpha tocopherol also reduced prostate cancer risk, but only when gamma tocopherol levels were high.1 Over the last 13 years, a myriad of studies have pointed to the urgent need for Americans to obtain sufficient gamma tocopherol. Yet the vast majority of human clinical research focuses only on alpha tocopherol—as if it were the only form of vitamin E people require. This article uncovers new research showing the ability of gamma tocopherol to combat conditions as diverse as asthma, cancer, metabolic syndrome, cardiovascular conditions, Alzheimer’s, and Parkinson’s disease. Differences Between Alpha and Gamma TocopherolAlpha tocopherol is the best known form of vitamin E and is found in the largest quantities in blood and tissue. It is critical, however, for anyone supplementing with vitamin E to make sure they are also getting adequate gamma tocopherol each day. The key benefit is gamma tocopherol’s ability to dramatically reduce inflammatory threats, a major cause of virtually all degenerative diseases. Current research supports the importance of gamma tocopherol in preventing numerous components of the degenerative diseases associated with aging.2,3
Although little known to the general public, gamma tocopherol is the form of vitamin E most prevalent in our natural diets. In addition to it’s impressive antioxidant capacity, gamma tocopherol possesses key functions critical to our well-being.4,5 It is now recognized that gamma tocopherol, like alpha tocopherol, is retained in the body and delivered to tissues.6 Gamma tocopherol has far more powerful anti-inflammatory actions than does the alpha form. Further, it is more potent at inhibiting certain inflammatory cytokines in cell culture and in living animals.7-9 And it inhibits production of stress-related “heat shock proteins” that result from inflammatory stimuli.10 Kidney dialysis patients, with huge inflammatory stresses, show reduced markers of inflammation when supplemented with gamma tocopherol.11 Enhanced Protection Against AtherosclerosisCardiovascular diseases are now recognized as the result of oxidative stress and inflammation at every stage. Gamma tocopherol is gaining the attention of cardiovascular scientists and clinicians because of its unique ability to block inflammation and to induce favorable changes in blood vessel function. As researchers now know, it is the oxidation of LDL that makes it such a dangerous atherogenic lipid in the blood. In a study comparing the effects of gamma vs. alpha tocopherol in preventing oxidation of LDL, scientists found that it was the gamma tocopherol that provided potent protection in every parameter.12 One of the most important benefits of gamma tocopherol is its ability to improve endothelial function by increasing nitric oxide synthase, the enzyme responsible for producing vessel-relaxing nitric oxide.12 One major way it produces this effect is by sponging up destructive reactive nitrogen species, such as peroxynitrite.13 In fact, gamma tocopherol is able to “trap” a variety of reactive nitrogen species and halt their negative effects on a host of cellular processes.14 The cumulative effect of all of these actions was shown in a study demonstrating that gamma tocopherol could prevent cerebral infarction (the most common type of stroke) in a mouse model.15
Supplementation in humans with only 100 mg per day of gamma tocopherol showed similar promise, demonstrating a reduction in several risk factors for arterial clotting such as platelet aggregation and LDL cholesterol.16 Another study using a daily supplement containing 800 mg of gamma tocopherol resulted in reduction of oxidative stress and inflammatory markers in adults with metabolic syndrome.3 Interestingly, the effects were even more pronounced when 800 mg of alpha tocopherol was added, demonstrating that both forms of vitamin E are synergistically vital for optimal cardiovascular health. Strenuous exercise, while beneficial for people in good physical shape, does tend to increase blood coagulation and platelet aggregation in sedentary individuals—a bad thing in people with pre-existing atherosclerosis. Gamma tocopherol supplementation can mitigate these effects, potentially lowering stroke and heart attack risk.17 Anti-Cancer EffectsJust as we saw with cardiovascular disease, gamma tocopherol exerts anti-cancer effects through a variety of important mechanisms, giving it an especially broad spectrum of action against a host of tumor types. At the very beginning of the cancer development process, gamma tocopherol traps reactive nitrogen species and other free radicals that cause mutations in DNA strands and render cells vulnerable to malignant transformation.18,19 This is a crucial step in the prevention of cancer. Gamma tocopherol inhibits cancer cell growth in culture through a number of different mechanisms.20 It down-regulates control molecules known as cyclins, which trap cancer cells in the midst of their reproduction cycle and prevent them from reproducing and spreading.21 This anti-cancer effect appears to be based on a mechanism separate from the vitamin’s well-known antioxidant powers. A cell membrane receptor called PPAR-gamma is a promising target for anticancer therapies because it affects genes that control cancer cell growth and death.22 This is why PPAR-activating drugs are being researched and developed by pharmaceutical companies as anti-cancer drugs. Gamma tocopherol is more powerful than alpha tocopherol at stimulating PPAR-gamma activity, especially in colon cancer cells.23,24 In prostate cancer cells, PPAR-gamma stimulation by gamma tocopherol resulted in a complete cessation of cancer cell growth.24
Once cancerous transformation has taken place, there are still biological opportunities to prevent full-blown tumor development. One of these ways is the induction of deliberate cell death through built-in genetic programs, a process called apoptosis. In a variety of cancer tissues, gamma tocopherol has been found to be superior to alpha tocopherol at inducing apoptosis, triggering a number of cell-death-inducing pathways.25,26 In prostate cancer cells, gamma tocopherol induced cell death by blocking synthesis of important cell membrane components.27 And gamma tocopherol also reduces the development of new blood vessel formation in tumors, depriving them of the nutrients they need to thrive.28 To date, all of these mechanisms have been shown to inhibit cancers of the colon, prostate, breast, and lung in animal models, with many more under active investigation.29 Human studies provide excellent confirmation of the unique chemoprotective effects of gamma tocopherol. A diet rich in walnuts, which contain gamma tocopherol (3 oz. contain 15.6 mg gamma tocopherol), produced a trend towards improvement in measurements of prostate-specific antigen (PSA)—a marker of prostate cancer.30 Note that one would have to eat massive amounts of walnuts each day (almost 2.5 pounds) to obtain optimal gamma tocopherol dosing. This is why supplementation with gamma tocopherol is an important component of any prevention program. | ||||||
Neurodegenerative Disease DefenseA particularly dangerous free radical known as reactive nitrogen species has been implicated in Alzheimer’s disease. High intakes of vitamins C and E have been associated with substantially lower risk of age-related neurodegenerative diseases such as Alzheimer’s.31,32 Gamma tocopherol scavenges reactive nitrogen species and may prove beneficial in reducing the impact of the disease.33 Neurodegenerative diseases also have a large inflammatory component. Human trials of supplemental vitamin E in neurodegenerative diseases have almost exclusively used alpha tocopherol, leading many experts to call for new studies using gamma tocopherol because of its more potent anti-inflammatory effects.5 In a mouse model of Parkinson’s disease, gamma tocopherol was more effective than alpha tocopherol at preventing loss of the essential neurotransmitter dopamine, the chemical defect that produces Parkinson’s symptoms.34 Combating Inflammatory Airway Diseases: Allergies and AsthmaAsthma and allergies are closely related conditions that are triggered by our immune system going into red alert in response to substances in the environment. In numerous studies, gamma tocopherol prevents migration of inflammatory cells into the airways at the beginning of an attack of asthma or allergic rhinitis, and also reduces overgrowth of mucous cells in the nose and upper airways.35 Gamma tocopherol supplementation decreases overall oxidative stress and suppresses excessive release of inflammatory cytokines in both normal and asthmatic human subjects.36
Oxidant molecules such as ozone are particularly dangerous for people who suffer from these inflammatory airway conditions.37 Studies of gamma tocopherol have shown broad anti-inflammatory effects in allergic animals experiencing airway inflammation by exposure to ozone.37,38 SummaryVitamin E is one of the earliest-known and best-studied vitamins. Published studies demonstrate that people with higher intakes of gamma tocopherol may achieve a considerable reduction in their risks of common age-related diseases. Regrettably, most health conscious individuals take only alpha tocopherol and are deprived of the optimal and synergistic benefits provided by the gamma tocopherol form of vitamin E. Human studies indicate benefits with supplemental doses ranging from 100 mg to 800 mg of gamma tocopherol a day. A review of the scientific literature indicates that most people should supplement with at least 200 mg of gamma tocopherol each day.1,39 If you have any questions on the scientific content of this article, please call a Life Extension® Wellness Specialist at 1-866-864-3027. | ||
| References | ||
| 1. Helzlsouer KJ, Huang HY, Alberg AJ, et al. Association between alpha-tocopherol, gamma-tocopherol, selenium, and subsequent prostate cancer. J Natl Cancer Inst. 2000 Dec 20;92(24):2018-23. 2. Reiter E, Jiang Q, Christen S. Anti-inflammatory properties of alpha- and gamma-tocopherol. Mol Aspects Med. 2007 Oct-Dec;28(5-6):668-91. 3. Devaraj S, Leonard S, Traber MG, Jialal I. Gamma-tocopherol supplementation alone and in combination with alpha-tocopherol alters biomarkers of oxidative stress and inflammation in subjects with metabolic syndrome. Free Radic Biol Med. 2008 Mar 15;44(6):1203-8. 4. Brigelius-Flohe R, Traber MG. Vitamin E: function and metabolism. FASEB J. 1999 Jul;13(10):1145-55. 5. Usoro OB, Mousa SA. Vitamin E forms in Alzheimer’s disease: a review of controversial and clinical experiences. Crit Rev Food Sci Nutr. 2010 May;50(5):414-9. 6. Galli F, Azzi A. Present trends in vitamin E research. Biofactors. 2010 Jan;36(1):33-42. 7. Devaraj S, Traber MG. Gamma-tocopherol, the new vitamin E? Am J Clin Nutr. 2003 Mar;77(3):530-1. 8. Jiang Q, Elson-Schwab I, Courtemanche C, Ames BN. gamma-tocopherol and its major metabolite, in contrast to alpha-tocopherol, inhibit cyclooxygenase activity in macrophages and epithelial cells. Proc Natl Acad Sci U S A. 2000 Oct 10;97(21):11494-9. 9. Jiang Q, Ames BN. Gamma-tocopherol, but not alpha-tocopherol, decreases proinflammatory eicosanoids and inflammation damage in rats. FASEB J. 2003 May;17(8):816-22. 10. Fischer CP, Hiscock NJ, Basu S, et al. Vitamin E isoform-specific inhibition of the exercise-induced heat shock protein 72 expression in humans. J Appl Physiol. 2006 May;100(5):1679-87. 11. Himmelfarb J, Phinney S, Ikizler TA, Kane J, McMonagle E, Miller G. Gamma-tocopherol and docosahexaenoic acid decrease inflammation in dialysis patients. J Ren Nutr. 2007 Sep;17(5):296-304. 12. Li D, Saldeen T, Romeo F, Mehta JL. Relative effects of alpha- and gamma-tocopherol on low-density lipoprotein oxidation and superoxide dismutase and nitric oxide synthase activity and protein expression in rats. J Cardiovasc Pharmacol Ther. 1999 Oct;4(4):219-26. 13. McCarty MF. Gamma-tocopherol may promote effective no synthase function by protecting tetrahydrobiopterin from peroxynitrite. Med Hypotheses. 2007;69(6):1367-70. 14. Saito F, Iwamoto S, Yamauchi R. Reaction products of gamma-tocopherol with (E)-4-oxo-2-nonenal in acidic acetonitrile. Biosci Biotechnol Biochem. 2010;74(1):168-74. 15. Mishima K, Tanaka T, Pu F, et al. Vitamin E isoforms alpha-tocotrienol and gamma-tocopherol prevent cerebral infarction in mice. Neurosci Lett. 2003 Jan 30;337(1):56-60. 16. Singh I, Turner AH, Sinclair AJ, Li D, Hawley JA. Effects of gamma-tocopherol supplementation on thrombotic risk factors. Asia Pac J Clin Nutr. 2007;16(3):422-8. 17. Vucinic L, Singh I, Spargo FJ, Hawley JA, Linden MD. Gamma tocopherol supplementation prevents exercise induced coagulation and platelet aggregation. Thromb Res. 2010 Feb;125(2):196-9. 18. Christen S, Woodall AA, Shigenaga MK, Southwell-Keely PT, Duncan MW, Ames BN. gamma-tocopherol traps mutagenic electrophiles such as NO(X) and complements alpha-tocopherol: physiological implications. Proc Natl Acad Sci U S A. 1997 Apr 1;94(7):3217-22. 19. Stone WL, Papas AM. Tocopherols and the etiology of colon cancer. J Natl Cancer Inst. 1997 Jul 16;89(14):1006-14. 20. Moyad MA, Brumfield SK, Pienta KJ. Vitamin E, alpha- and gamma-tocopherol, and prostate cancer. Semin Urol Oncol. 1999 May;17(2):85-90. 21. Gysin R, Azzi A, Visarius T. Gamma-tocopherol inhibits human cancer cell cycle progression and cell proliferation by down-regulation of cyclins. FASEB J. 2002 Dec;16(14):1952-4. 22. Campbell SE, Stone WL, Whaley SG, Qui M, Krishnan K. Gamma (gamma) tocopherol upregulates peroxisome proliferator activated receptor (PPAR) gamma (gamma) expression in SW 480 human colon cancer cell lines. BMC Cancer. 2003 Oct 1;3:25. 23. Stone WL, Krishnan K, Campbell SE, Qui M, Whaley SG, Yang H. Tocopherols and the treatment of colon cancer. Ann N Y Acad Sci. 2004 Dec;1031:223-33. 24. Campbell SE, Musich PR, Whaley SG, et al. Gamma tocopherol upregulates the expression of 15-S-HETE and induces growth arrest through a PPAR gamma-dependent mechanism in PC-3 human prostate cancer cells. Nutr Cancer. 2009;61(5):649-62. 25. Jiang Q, Wong J, Ames BN. Gamma-tocopherol induces apoptosis in androgen-responsive LNCaP prostate cancer cells via caspase-dependent and independent mechanisms. Ann N Y Acad Sci. 2004 Dec;1031:399-400. 26. Takahashi S, Takeshita K, Seeni A, et al. Suppression of prostate cancer in a transgenic rat model via gamma-tocopherol activation of caspase signaling. Prostate. 2009 May 1;69(6):644-51. 27. Jiang Q, Wong J, Fyrst H, Saba JD, Ames BN. Gamma-tocopherol or combinations of vitamin E forms induce cell death in human prostate cancer cells by interrupting sphingolipid synthesis. Proc Natl Acad Sci U S A. 2004 Dec 21;101(51):17825-30. 28. Wells SR, Jennings MH, Rome C, Hadjivassiliou V, Papas KA, Alexander JS. Alpha-, gamma- and delta-tocopherols reduce inflammatory angiogenesis in human microvascular endothelial cells. J Nutr Biochem. 2010 Jul;21(7):589-97. 29. Ju J, Picinich SC, Yang Z, et al. Cancer-preventive activities of tocopherols and tocotrienols. Carcinogenesis. 2010 Apr;31(4):533-42. 30. Spaccarotella KJ, Kris-Etherton PM, Stone WL, et al. The effect of walnut intake on factors related to prostate and vascular health in older men. Nutr J. 2008;7:13. 31. Engelhart MJ, Geerlings MI, Ruitenberg A, et al. Dietary intake of antioxidants and risk of Alzheimer disease. JAMA. 2002 Jun 26;287(24):3223-9. 32. Morris MC, Evans DA, Tangney CC, et al. Relation of the tocopherol forms to incident Alzheimer disease and to cognitive change. Am J Clin Nutr. 2005 Feb;81(2):508-14. 33. Williamson KS, Gabbita SP, Mou S, et al. The nitration product 5-nitro-gamma-tocopherol is increased in the Alzheimer brain. Nitric Oxide. 2002 Mar;6(2):221-7. 34. Itoh N, Masuo Y, Yoshida Y, Cynshi O, Jishage K, Niki E. gamma-Tocopherol attenuates MPTP-induced dopamine loss more efficiently than alpha-tocopherol in mouse brain. Neurosci Lett. 2006 Jul 31;403(1-2):136-40. 35. Wagner JG, Jiang Q, Harkema JR, et al. Gamma-tocopherol prevents airway eosinophilia and mucous cell hyperplasia in experimentally induced allergic rhinitis and asthma. Clin Exp Allergy. 2008 Mar;38(3):501-11. 36. Wiser J, Alexis NE, Jiang Q, et al. In vivo gamma-tocopherol supplementation decreases systemic oxidative stress and cytokine responses of human monocytes in normal and asthmatic subjects. Free Radic Biol Med. 2008 Jul 1;45(1):40-9. 37. Wagner JG, Jiang Q, Harkema JR, et al. Ozone enhancement of lower airway allergic inflammation is prevented by gamma-tocopherol. Free Radic Biol Med. 2007 Oct 15;43(8):1176-88. 38. Wagner JG, Harkema JR, Jiang Q, Illek B, Ames BN, Peden DB. Gamma-tocopherol attenuates ozone-induced exacerbation of allergic rhinosinusitis in rats. Toxicol Pathol. 2009;37(4):481-91. 39. Hensley K, Benaksas EJ, Bolli R, et al. New perspectives on vitamin E: gamma-tocopherol and carboxyelthylhydroxychroman metabolites in biology and medicine. Free Radic Biol Med. 2004 Jan 1;36(1):1-15. |